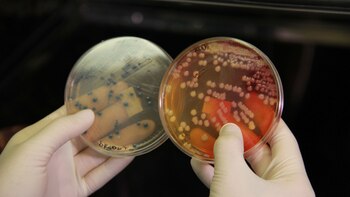
Antes de llegar a la
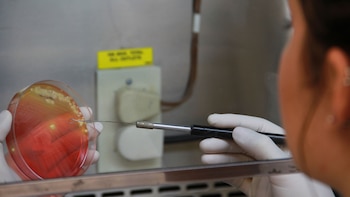
Los expertos en seguridad alimentaria

Antes de llegar a la mesa de cada familia, buena parte de los alimentos que se consumen debieron superar diversas pruebas que garanticen su calidad y seguridad. Para ello, los expertos en seguridad alimentaria buscan microorganismos patógenos que pudieran estar presentes en los víveres que, de ser ingeridos, podrían provocar en el consumidor alguna enfermedad transmitida por alimentos (ETA). En ese sentido, "es muy importante controlar en cuanto al nivel de contaminación los alimentos que consumimos", señaló la doctora Adriana Súcari, bioquímica especialista en microbiología y presidente de la Sociedad Argentina de Bacteriología, Micología y Parasitología Clínica (SADEBAC).
"Normalmente controlamos todos los productos de la industria cárnica como las carnes crudas y otros productos derivados listos para consumo. También se estudian vegetales, otros alimentos listos para consumo y productos lácteos. Además, se realizan controles en alimentos para mascotas", agregó.
Qué ocurre cuando se detecta algo
Este tipo de controles no los encarga el consumidor final de los alimentos sino las empresas productoras de los mismos. Si en alguna de las pruebas de laboratorio se obtuviera un resultado positivo, se evita la salida de esos productos al mercado. De acuerdo a la especialista "no lo pueden vender en las condiciones en las que están porque saben que hay algún agente patógeno. Por este motivo, no se libera al mercado y esa mercadería no se comercializa".
Una de las principales preocupaciones en lo relativo a la ingesta de algunos gérmenes que pudieran estar presentes, sobre todo en la carne, es el del síndrome urémico hemolítico (SUH), una enfermedad causada por una bacteria llamada Escherichia coli O157:H7, productora de una toxina, que suele estar presente en los alimentos y en el agua. Tanto en niños como en adultos, ésta es una enfermedad grave que trae muchas complicaciones.
Puede presentarse a través de síntomas como diarrea, dolores abdominales, vómitos y otros más severos como diarrea sanguinolenta y deficiencias renales. La complicación de la enfermedad afecta particularmente a niños, ancianos y aquellos que, por padecer otras enfermedades, tienen su sistema inmunológico deprimido. En algunos casos, puede provocar la muerte.

En Argentina, este síndrome es endémico y se producen un promedio de entre 300 a 500 casos nuevos por año, lo que representa una incidencia anual promedio de 1 caso cada 100.000 habitantes. De acuerdo al Boletín Integrado de Vigilancia Epidemiológica que publica el Ministerio de Salud de la Nación, durante 2017 hasta la semana epidemiológica 40, se notificaron 228 casos de SUH, 184 casos corresponden a menores de 5 años.
Las personas pueden contraer esta bacteria a través de la ingesta de alimentos contaminados, como carne picada de vaca y aves sin cocción completa como las hamburguesas, embutidos, arrollados de carne, leche sin pasteurizar, productos lácteos elaborados a partir de leche sin pasteurizar, aguas contaminadas, lechuga, repollo y otros vegetales que se consumen crudos sin la adecuada limpieza y desinfección. También se puede producir el contagio de persona a persona por prácticas higiénicas inadecuadas.

Esto motiva reforzar la recomendación de asegurar una correcta manipulación y cocción adecuada de las carnes, además de un adecuado manejo de otros alimentos y el lavado de manos antes y después de manipular alimentos, sobre todo para quienes conviven con niños menores a cinco años. Respecto a la seguridad de los alimentos, la experta refirió que "este problema no está solo en la carne sino también en los vegetales y otros alimentos. Es bastante frecuente. Se hacen ensayos de laboratorio antes de la liberación de los productos alimenticios a los mercados de consumo".
En la actualidad, además, "hay algo muy importante que es un cambio en el Código Alimentario Argentino ya que antes solo se detectaba Escherichia coli O157:H7, la bacteria más conocida que produce SUH. Ahora estos controles se ampliaron y se exige la detección de otras E. Coli que también producen verotoxina y pueden provocar la enfermedad", agregó.
¿Qué pasa con los lácteos?

La leche y los lácteos, como yogures y quesos también son sometidos a diversos controles microbiológicos para garantizar su seguridad. "Es muy importante asegurar la ausencia de patógenos en este tipo de alimentos, como también lo es que, cuando se trata de una leche envasada en condiciones de esterilidad, no haya ningún tipo de bacteria. Para estos casos, se hace un recuento de bacterias totales que debería arrojar un resultado negativo", destacó Súcari.
Controles de exportación

Argentina es un país exportador de alimentos, principalmente carne, a mercados como los de los países de la Comunidad Europea, donde "hay una exigencia muy grande en cuando a los productos que reciben desde otros países. Como ellos la controlan también en el puerto de entrada, siempre antes de liberar los contenedores hacia el viejo continente, los frigoríficos hacen controles principalmente para descartar la presencia de E. Coli productora de verotoxina, sumado a otros patógenos que tienen que estar ausentes", destacó la experta.
LEA MÁS:
¿Es posible una alimentación saludable en las fiestas?
VIH: ¿Por qué es importante hacerse el test y cómo se interpretan los resultados?
¿Por qué es importante vacunarse contra la gripe?
Enfermedades respiratorias: claves para reconocerlas y tratarlas
Últimas Noticias
Metro CDMX y Metrobús hoy 9 de diciembre
Información y actualización del servicio de transporte público en la capital este martes

Los eléctricos más vendidos en Colombia en noviembre de 2025: Tesla entra al ranking, aunque con matices
El mercado eléctrico tuvo un noviembre histórico y consolidó su mejor año, en el que BYD y otras marcas asiáticas lideran con fuerza, mientras Tesla entra al listado

Cónclave en Casa Rosada: Adorni convocó a Bullrich y Martín Menem a horas de presentar las reformas libertarias de Milei
La reunión será en el despacho del jefe de Gabinete. Se terminarán de discutir la estrategia política para las sesiones extraordinarias. El trasfondo de la reunión

Efemérides del 9 de diciembre: la muerte de Jenni Rivera y otros sucesos que marcaron la humanidad
Eventos que cambiaron el camino de la historia y que se recuerdan este inicio de semana

Ilia Topuria se une a Cristiano Ronaldo en un nuevo negocio deportivo: su nuevo horizonte empresarial entre rumores de crisis
El luchador se encuentra en un parón profesional tras haber anunciado que necesita estabilizar su vida personal



